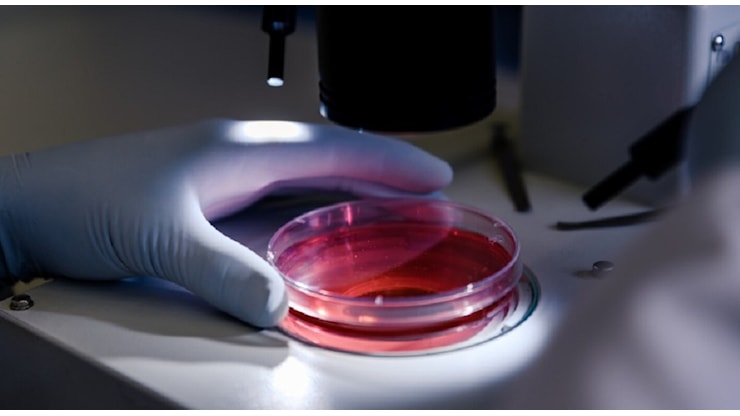
Donatore di sperma ha una mutazione genetica che aumenta il rischio di cancro, nati 200 bambini in 14 nazioni diverse: «Alcuni sono già morti» - Corriere Adriatico

Scandalo in Europa: sperma a rischio cancro ha dato vita a quasi 200 bambini

Articolo Precedente

Articolo Successivo

 Redazione Salute
-
Una rete di giornalismo investigativo, coordinata dalla European Broadcasting Union e composta da quattordici emittenti televisive tra cui la Bbc, ha portato alla luce un caso che solleva interrogativi profondi sul sistema delle donazioni di gameti.
Redazione Salute
-
Una rete di giornalismo investigativo, coordinata dalla European Broadcasting Union e composta da quattordici emittenti televisive tra cui la Bbc, ha portato alla luce un caso che solleva interrogativi profondi sul sistema delle donazioni di gameti.
L’inchiesta, condotta a livello continentale, rivela come lo sperma di un unico donatore, portatore di una grave mutazione genetica ereditaria che moltiplica esponenzialmente le probabilità di sviluppare tumori, sia stato utilizzato per concepire almeno 197 bambini in diversi Paesi europei.
La banca del seme danese coinvolta, dopo aver commercializzato il materiale biologico per anni, è stata allertata su una prima diagnosi di cancro in un bambino solo nell'aprile del 2020, scoprendo così, a posteriori, la pericolosa anomalia genetica del donatore. panorama +3
La dinamica di una diffusione inconsapevole
Il donatore, che operava sotto lo pseudonimo di Kjeld, era stato regolarmente reclutato e retribuito a partire dal 2005 dalla Denmark’s European Sperm Bank, una delle strutture più grandi del mondo nel suo settore.
L'uomo, all'epoca uno studente, era totalmente ignaro di essere portatore di questa specifica mutazione, la quale, pur non avendo necessariamente manifestato la malattia in lui, si trasmette alla progenie con un altissimo rischio di sviluppare forme tumorali in giovane età.
La procedura, che inizialmente sembrava rispettare i protocolli, si è rivelata un veicolo di diffusione involontaria di una condizione genetica devastante, i cui effetti si sono materializzati solo dopo la nascita di numerosi figli in diverse nazioni. corriereadriatico +3
Le conseguenze sulla prole e le omissioni
Alcuni dei bambini nati da quella donazione, purtroppo, si sono già ammalati di cancro, e in casi estremi non hanno sopravvissuto alla malattia, morendo in giovanissima età.
La tragedia, che assume dimensioni collettive, sta nel fatto che la mutazione comporta una predisposizione così elevata che solo una parte minoritaria dei nati potrebbe non esserne colpita nel corso della vita.
L'episodio getta una luce cruda sulle possibili falle nei controlli sanitari preventivi e sui limiti della tracciabilità nelle catene di distribuzione dei gameti, le quali, seppur regolamentate, hanno permesso che un singolo profilo genetico ad alto rischio venisse utilizzato su una scala così ampia prima che qualsiasi campanello d'allarme suonasse. corriereadriatico +3
Le implicazioni per il sistema delle donazioni
Questo scandalo, che ha dell'incredibile, non è un fatto isolato di cronaca nera ma rappresenta piuttosto il sintomo di una vulnerabilità sistemica.
Pone questioni stringenti in merito alla profondità degli screening genetici obbligatori per i donatori, alla tempestività con cui le banche aggiornano i protocolli alla luce di nuove scoperte scientifiche e alla trasparenza verso le famiglie che ricorrono a queste tecniche.
L'assenza di dettagli espliciti sulle singole vicende non attenua la gravità della situazione, che coinvolge quasi duecento nuclei familiari, i quali oggi devono confrontarsi con una prospettiva di salute per i propri figli segnata da un'incertezza drammatica e da un pericolo concreto, originato da una pratica che avrebbe dovuto garantire sicurezza e speranza. corriereadriatico +3




